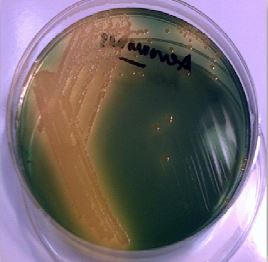
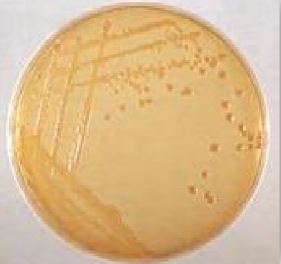

النبات

مواضيع عامة في علم النبات

الجذور - السيقان - الأوراق

النباتات الوعائية واللاوعائية

البذور (مغطاة البذور - عاريات البذور)

الطحالب

النباتات الطبية


الحيوان

مواضيع عامة في علم الحيوان

علم التشريح

التنوع الإحيائي

البايلوجيا الخلوية


الأحياء المجهرية

البكتيريا

الفطريات

الطفيليات

الفايروسات


علم الأمراض

الاورام

الامراض الوراثية

الامراض المناعية

الامراض المدارية

اضطرابات الدورة الدموية

مواضيع عامة في علم الامراض

الحشرات


التقانة الإحيائية

مواضيع عامة في التقانة الإحيائية


التقنية الحيوية المكروبية

التقنية الحيوية والميكروبات

الفعاليات الحيوية

وراثة الاحياء المجهرية

تصنيف الاحياء المجهرية

الاحياء المجهرية في الطبيعة

أيض الاجهاد

التقنية الحيوية والبيئة

التقنية الحيوية والطب

التقنية الحيوية والزراعة

التقنية الحيوية والصناعة

التقنية الحيوية والطاقة

البحار والطحالب الصغيرة

عزل البروتين

هندسة الجينات


التقنية الحياتية النانوية

مفاهيم التقنية الحيوية النانوية

التراكيب النانوية والمجاهر المستخدمة في رؤيتها

تصنيع وتخليق المواد النانوية

تطبيقات التقنية النانوية والحيوية النانوية

الرقائق والمتحسسات الحيوية

المصفوفات المجهرية وحاسوب الدنا

اللقاحات

البيئة والتلوث


علم الأجنة

اعضاء التكاثر وتشكل الاعراس

الاخصاب

التشطر

العصيبة وتشكل الجسيدات

تشكل اللواحق الجنينية

تكون المعيدة وظهور الطبقات الجنينية

مقدمة لعلم الاجنة


الأحياء الجزيئي

مواضيع عامة في الاحياء الجزيئي


علم وظائف الأعضاء


الغدد

مواضيع عامة في الغدد

الغدد الصم و هرموناتها

الجسم تحت السريري

الغدة النخامية

الغدة الكظرية

الغدة التناسلية

الغدة الدرقية والجار الدرقية

الغدة البنكرياسية

الغدة الصنوبرية

مواضيع عامة في علم وظائف الاعضاء

الخلية الحيوانية

الجهاز العصبي

أعضاء الحس

الجهاز العضلي

السوائل الجسمية

الجهاز الدوري والليمف

الجهاز التنفسي

الجهاز الهضمي

الجهاز البولي


المضادات الميكروبية

مواضيع عامة في المضادات الميكروبية

مضادات البكتيريا

مضادات الفطريات

مضادات الطفيليات

مضادات الفايروسات

علم الخلية

الوراثة

الأحياء العامة

المناعة

التحليلات المرضية

الكيمياء الحيوية

مواضيع متنوعة أخرى

الانزيمات
الجنس Aeromonas Spp
المؤلف:
عبد الرزاق سليمان التومي ، محمد محمد الامام ، عبد الباسط رمضان
المصدر:
اساسيات التشخيص البكتريولوجي المعملي والسريري
الجزء والصفحة:
13-7-2016
4498
Aeromonas Spp
وهي عبارة عن عصيات يتراوح حجمها ما بين 0.3 – 0.1 ميكرومتر سالبة لصيغة جرام، غير مكونة للأبواع كما أنها إختيارية التهوية وتتواجد بصورة كبيرة في خزانات المياه العذبة والتربة كما يمكن أن تتواجد البكتيريا الممرضة في بيئة المياه البحرية . وينقسم هذا الجنس البكتيري إلى مجموعتين تعرفان بالمجموعة المتحركة المحبة للبرودة وهي ممرضة للأسماك والمجموعة الأخرى غير المتحركة وهي محبة للحرارة المعتدلة وتفضل النمو في درجات حرارة ما بين 38-15 درجة مئوية مثل النوع البكتيري Aeromonas hydrophila والنوع البكتيري Aeromonas cavai وكذلك النوع البكتيري Aeromonas sobria وهذه الأنواع الثلاثة ممرضة للإنسان ولها أهميتها في الصناعات الغذائية.

خلايا النوع البكتيري Aeromonas hydrophila
يتواجد هذا الجنس البكتيري بصورة كبيرة في البيانات المائية. في خلال الفصول الباردة من السنة، كما يتواجد في مياه الصرف الصحي بأعداد كبيرة على مدار السنة ويختلف معدل تواجده حسب المتغيرات البيئية، ففي الظروف البيئية الاعتيادية يتواجد هذا الجنس البكتيري بمعدل 102 – 1 وحدة تكوين المستعمرات في كل مليلتر في البرك وخزانات المياه، ويعتبر النوع البكتيري A. caviae أكثرهم شيوعاً في مياه الصرف الصحي وهذه المياه غالباً ما تستعمل في ري المحاصيل الزراعية كما يتم تصريفها في البحار مما يجعل من المفيد استعماله في معرفة مدى تلوث مياه الشرب بمياه الصرف الصحي.
ومن الملاحظ أن النوع البكتيري A. hydrophila والنوع البكتيري A. sobria أكثر سمية من النوع البكتيري A. caviae ويعتبر النوع البكتيري A. hydrophila والنوع البكتيري A. caviae من اكثر أنواع هذا الجنس البكتيري قليلة بمعدل حوالي 35 وحدة تكوين المستعمرات في كل 100 مليلتر.
بصور عامة فإن هذه البكتيريا تتأثر بوجود الكلور والكلورامين أكثر من بقية أفراد العائلة المعوية، ومن خلال الدراسات التي أجريت اتضح قدرة النوع البكتيري A. hydrophila المتواجد في الغشاء الحيوي biofilm على مقاومة تركيز 0.3 مليجرام لكل لتر من محلول الكلورامين الأحادي كما تبين قدرته على البقاء في وجود 0.6 مليجرام من محلول الكلورامين الأحادي.
الامراضية :
يعتبر هذا الجنس البكتيري انتهازي opportunistic ويسبب تجرثم الدم المدمي القاتل fatal haemorrhagic septicaemia ، بالإضافة لذلك فإن الإصابة بهذا البكتيري الممرض في الغالب يصاحب الكوارث الطبيعية (مثل الزلازل، الأعاصير، ...) فقد تبين أنه المسئول عن التهاب البروستات prostatitis إصابات جهاز البولي المدمي haemolytic syndrome uraemic كما يلعب دور مهم في احداث الإصابة بالنزلات المعوية gastroenteritis .
التشخيص المعملي :
بالرغم من أن الجنس البكتيري Aeromonas Spp يعطي نتيجة موجبة لإختيار Oxidase test كما هو الحالة في النوع البكتيري Vibrio cholera إلا أنه يختلف عن هذا النوع البكتيري بقدرته على تكسير الأسكولين (hydrolyze aesculin).
ــ الوسط الغذائي TCBS : المستعمرات البكتيرية النامية تكون صغيرة الحجم وبلون أصفر.
مستمرات Aeromonas Spp على TCBS agar
ــ الوسط الغذائي Blood agar : المستعمرات البكتيرية A. hydrophial النامية تكون تحلل لكريات الدم الحمراء الكامل (B haemolysis).
مستعمرات Aeromonas Spp على Blood agar
ـ الوسط الغذائي MacConkey agar : المستعمرات البكتيرية النامية ليس لها القدرة على تخمير سكر اللاكتوز فبذلك يكون لونها باهت.
مستعمرات Aeromonas Spp على MacConkey agar

الاكثر قراءة في البكتيريا
اخر الاخبار
اخبار العتبة العباسية المقدسة
الآخبار الصحية

قسم الشؤون الفكرية يصدر كتاباً يوثق تاريخ السدانة في العتبة العباسية المقدسة
"المهمة".. إصدار قصصي يوثّق القصص الفائزة في مسابقة فتوى الدفاع المقدسة للقصة القصيرة
(نوافذ).. إصدار أدبي يوثق القصص الفائزة في مسابقة الإمام العسكري (عليه السلام)